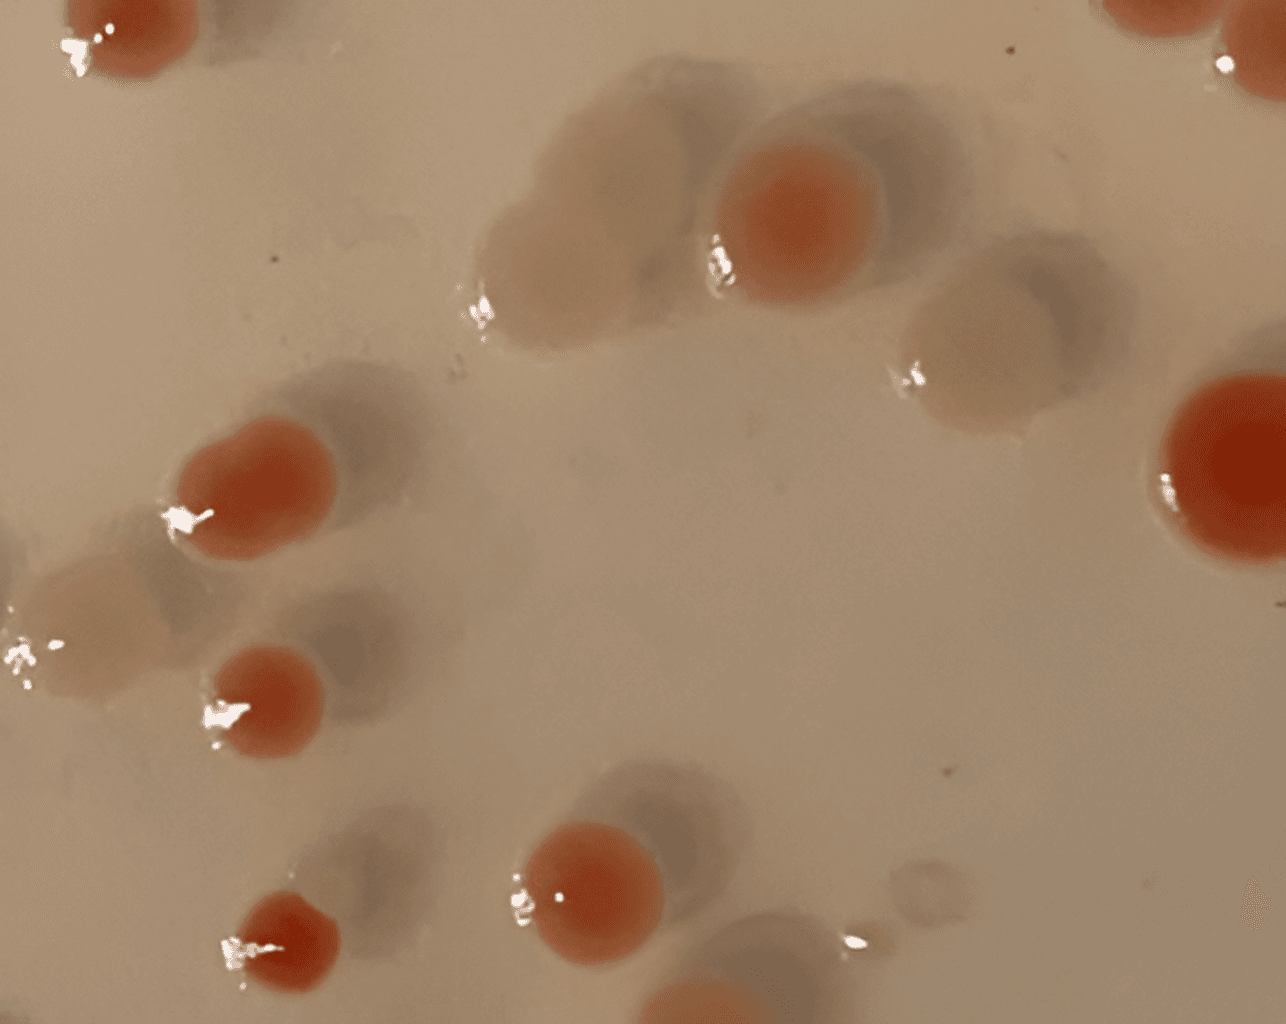
Lycopene-producing E. coli colonies — 14-fragment pathway assembled with F1-X™

F1-X™Next-Generation Gibson Assembly
Same protocol. Validated fidelity. Better price.

Scientist-Led
Built by PhDs, Inventor-Advised
Made in USA
In-House Manufacturing & QC
NGS-Verified
Sequence-Validated Every Lot
Global Reach
7+ Partners Worldwide
PRICING
Simple, Transparent Pricing.
NEBuilder® HiFi: $18.60/rxn at 10-rxn scale — competitor pricing sourced from manufacturer website as of March 2026, subject to change.
Interested in buying in bulk? Contact us today
PERFORMANCE
Explore Performance Data
Proven Fidelity, Better Price
In internal benchmarks, achieves parity or higher fidelity than NEBuilder® HiFi, GeneArt™ Gibson Assembly HiFi, and the original Gibson Assembly® Cloning Kit in a 4-fragment head-to-head — at a fraction of the cost. Validated by Oxford Nanopore whole-plasmid sequencing.
Multi-Fragment Power
95–97% cloning efficiency maintained across 4, 7, 9, and 11 fragment assemblies in a single step. Demonstrated up to 14 fragments (9 kb lycopene pathway, de novo). No protocol changes.
Freeze-Thaw Robust
After 5 freeze-thaw cycles: ~95% efficiency, error rate 2.7–7.8 × 10⁻⁵ errors/bp — well below input synthetic DNA error rate. Glycerol formulation stays liquid at −20°C.
Automation Compatible
Single-tube, isothermal reaction drops directly into liquid-handling and LIMS-linked workflows. Consistent results in 96-well plates at miniaturized, sub-20 µL reaction volumes.
Developed with scientific input from Dr. Dan Gibson, inventor of Gibson Assembly® and Racer board member.
APP NOTE
Example: 14-Fragment Pathway Assembly
9 kb lycopene biosynthesis construct assembled in one reaction using F1-X™ — no vector isolation, no restriction digests, no gel purification.
THE RACER PLATFORM